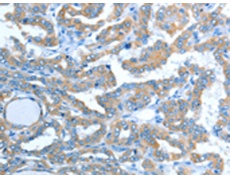
一抗

中文名稱:兔抗ALDH1B1多克隆抗體
英文名稱: Anti-ALDH1B1 rabbit polyclonal antibody
別 名: ALDH5; ALDHX
相關類別: 一抗
儲 存: 冷凍(-20℃)
抗 原: ALDH1B1
宿 主: Rabbit
反應種屬: Human
標 記 物: Unconjugate
克隆類型: rabbit polyclonal
技術規(guī)格
|
Background: |
This protein belongs to the aldehyde dehydrogenases family of proteins. Aldehyde dehydrogenase is the second enzyme of the major oxidative pathway of alcohol metabolism. This gene does not contain introns in the coding sequence. The variation of this locus may affect the development of alcohol-related problems. |
|
Applications: |
ELISA, WB |
|
Name of antibody: |
ALDH1B1 |
|
Immunogen: |
Synthetic peptide of human ALDH1B1 |
|
Full name: |
aldehyde dehydrogenase 1 family, member B1 |
|
Synonyms: |
ALDH5; ALDHX |
|
SwissProt: |
P30837 |
|
ELISA Recommended dilution: |
2000-5000 |
|
WB Predicted band size: |
57 kDa |
|
WB Positive control: |
Human liver cancer tissue |
|
WB Recommended dilution: |
500-2000 |


 購物車
購物車 幫助
幫助
 021-54845833/15800441009
021-54845833/15800441009